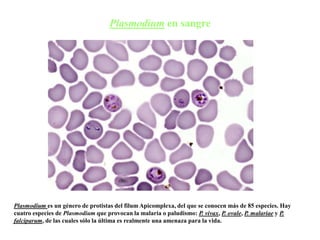
Plasmodium en sangre
Plasmodium es un género de protistas del filum Apicomplexa, del que se conocen más de 85 especies. Hay
cuatro especies de Plasmodium que provocan la malaria o paludismo: P. vivax, P. ovale, P. malariae y P.
falciparum, de las cuales sólo la última es realmente una amenaza para la vida.

El documento proporciona información sobre el reino Protista. Los protistas son organismos eucariotas unicelulares o pluricelulares simples que incluyen algas y protozoos. Se caracterizan por tener células eucariotas con organelas como mitocondrias, cloroplastos y corpúsculos basales. Algunos son autótrofos por fotosíntesis mientras que otros son heterótrofos por ingestión u absorción. Los protistas exhiben diversas formas de nutrición, reproducción y movilidad.